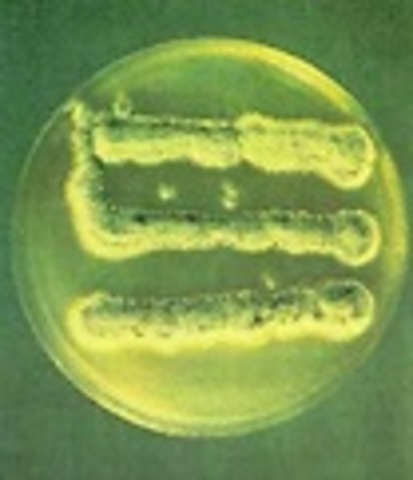
descubrimiento de la 2-	Penicilina.

-
...La primera maquina de vapor que tenia realmente fines prácticos fue la creada en el año 1712 por Thomas Newcomen. El escocés James Watt, fabricante de instrumentos, mejoró la maquIna
-
locomotora construida por George Stephenson y su hijo Robert en 1829. Se hizo famosa porque ganó el concurso de Rainhill y porque contaba con caja de fuego, caldera pirotubular alrededor del hogar y tiro forzado, todos ellos elementos de construcción esenciales que se conservaron hasta el final de la era de las locomotoras de vapor
-
-
elADN fue aislado por primera ves en el invierno de 1869 por el cientifico Friedrich Miescher
-
La historia de los rayos X comienza con los experimentos del científico británico William Crookes,pero no fue hasta 1895 cuando se pudieron evidenciar; por parte del físico Wilhelm Conrad Roentgen
-
fue un automóvil de bajo costo producido por Ford Motor Company de Henry Ford desde 1908 , lo cual provoco ila ntrodujo de la producción en cadena, popularizando la adquisición de los automóviles.
-
se atribuye a Alexander Fleming el descubrimiento de la penicilina mediante la observación y la experiencia a conocer y emplear las propiedades bactericidas de los mohos.
-
uno de los primeros fabricados en el Reino Unido,ejecuto su primer programa el 10 de mayo de 1950
-
el decimo vuelo fue realizado el 18 de mayo de 1969 a cargo de Thomas P. Stafford, John W. Young y Eugene A. Cernan
-
primer misil de combate de largo alcanse,Diseñados por Wernher von Braun,muchos de estos misiles fueron disparados desde las costas francesas hacia Londres
A list shows items. A timeline shows sequence.
Use Timetoast to make dates, milestones, and turning points easier to understand in a clear visual format. Timetoast is a timeline maker for work, school, research, and stories.